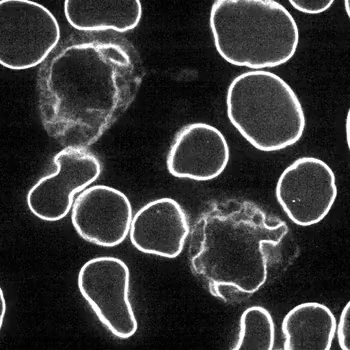
秦皇岛润泽医院

秦皇岛润泽医院
秦皇岛润泽医院
特色项目
CHARACTERISTIC PROJECT
再生抗衰
- 人体再生力是组织细胞功能自我恢复的能力。
- 干细胞技术是近年来生物医学领域的重大突破,可有效实现细胞、组织和器官的再生,对抗衰老、提升活力。
- 人体再生力的基础 - 干细胞
- 干细胞(stem cell, SC)是一类能够自我更新并分化形成多种组织细胞类型的多潜能原始细胞。
- 人体干细胞的数量随着机体的新陈代谢和生长不断减少:
- 婴儿时期:共约60亿个干细胞(1个干细胞/500个细胞)
- 25岁左右:共约10亿个干细胞(1个干细胞/5万个细胞)
- 50岁左右:共约3亿个干细胞(1个干细胞/20-50万个细胞)
- 随着年龄的增长及时补充干细胞可以达到抗衰老、保持机体年轻态的目的。
- 当机体某一功能衰退或完全丧失后,干细胞的存在或被输入(移植),有可能使机体恢复该功能,并通过修复受损组织,激活休眠细胞,调节内分泌,改善睡眠质量,提升免疫力和抵抗力。
- 间充质干细胞(MSC):是临床应用最多的一种多能干细胞,具有多向分化潜能、造血支持和促进干细胞植入、免疫调控和自我复制等特点。
- 间充质干细胞来源:脐带、骨髓、脂肪、脐带血、羊膜、胎盘、牙髓、外周血等。
- 间充质干细胞在临床应用范围非常广。
- 借助干细胞技术提升人体再生力是维护健康、预防疾病、促进康复、实现长寿的终极解决手段之一。